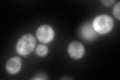
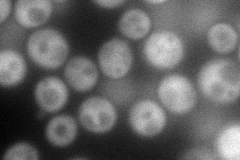
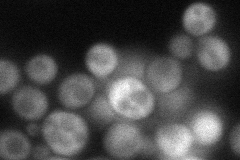

View description
Phosphatase subunit of the trehalose-6-phosphate synthase/phosphatase complex, which synthesizes the storage carbohydrate trehalose; expression is induced by stress conditions and repressed by the Ras-cAMP pathway
Localization:
Intensity:
Fold change:
Significance:
-
C’ GFP library in SD
cytosol141.13 -
N' NOP1pr-GFP in SD
cytosol105.471 -
N' TEF2pr-mCherry in SD

cytosol101.283 -
N' NATIVEpr-GFP in SD
cytosol56.977 -
N' TEF2pr-VC and Cyto-VN in SD

#N/A0 -
C’ GFP library in SD+DTT

cytosol275.051.94Yes -
C’ GFP library in SD+H2O2

cytosol184.471.3No -
C’ GFP library in Starvation Media

cytosol341.952.42Yes -
C’ GFP library on the background of Pup2-DaMP

cytosol -
C’ GFP library on the background of CCT mutant

cytosol154.2761.09313No
